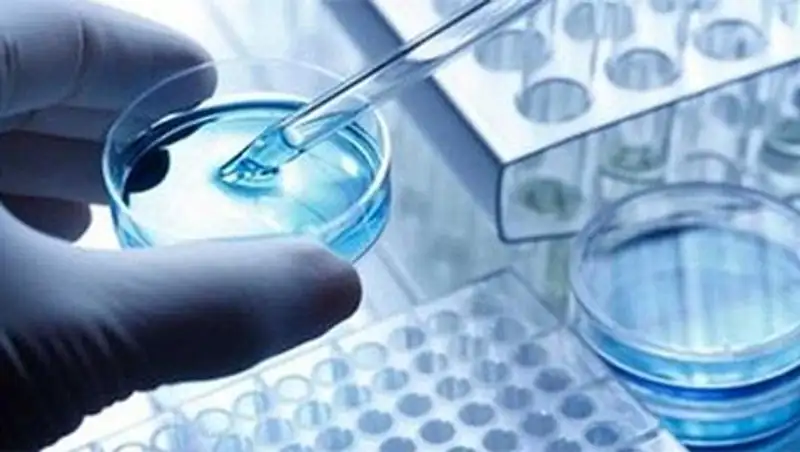
Восточноказахстанцы могут пройти независимую медицинскую экспертизу

Судебно-медицинская экспертиза передана из минздрава в минюст
 Zakon.kz
Zakon.kz
Таким образом будут созданы условия для большей независимости экспертов от сотрудников правоохранительных органов.
Судебно-экспертная система Казахстана реформируется по опыту Беларуси, сообщил директор центра судебной экспертизы министерства юстиции РК Исидор Борчашвили, передает КазТАГ.
«Республика Беларусь – одна из первых стран СНГ, где был создан государственный комитет судебных экспертиз, в котором объединены все экспертные учреждения. И в этом аспекте намерены двигаться и мы», - пояснил И. Борчашвили.
По его словам, в рамках реформирования правоохранительной системы с 1 января 2015 года из ведома минздрава передана в минюст судебно-медицинская экспертиза, с 1 июля 2015 года - судебно-наркологическая экспертиза, с 1 июля 2016 года в минюст будет передана и судебно-психиатрическая экспертиза.
«То есть мы тоже готовимся создать единое судебно-экспертное учреждение», - подчеркнул И. Борчашвили.
Он полагает, что таким образом будут созданы условия для большей независимости экспертов от сотрудников правоохранительных органов.
«До недавнего времени экспертные учреждения были во всех правоохранительных органах. Например, сотрудники МВД сами возбуждали уголовное дело, сами расследовали, сами назначали экспертизу и сами же ее проводили. Понятно, что в этом случае эксперты находились под влиянием своих структурных подразделений. А сейчас, поскольку они переведены в самостоятельную структуру, выведены из подчинения правоохранительных органов, независимость, соблюдение прав и законных интересов, с моей точки зрения, значительно увеличиваются», - считает И. Борчашвили.
Между министерством юстиции РК и государственным комитетом судебных экспертиз Республики Беларусь подписано межведомственное соглашение о сотрудничестве в области судебной экспертизы.
Фото: szepc.ru.
Поделитесь новостью
Читайте также
Если вы видите данное сообщение, значит возникли проблемы с работой системы комментариев. Возможно у вас отключен JavaScript